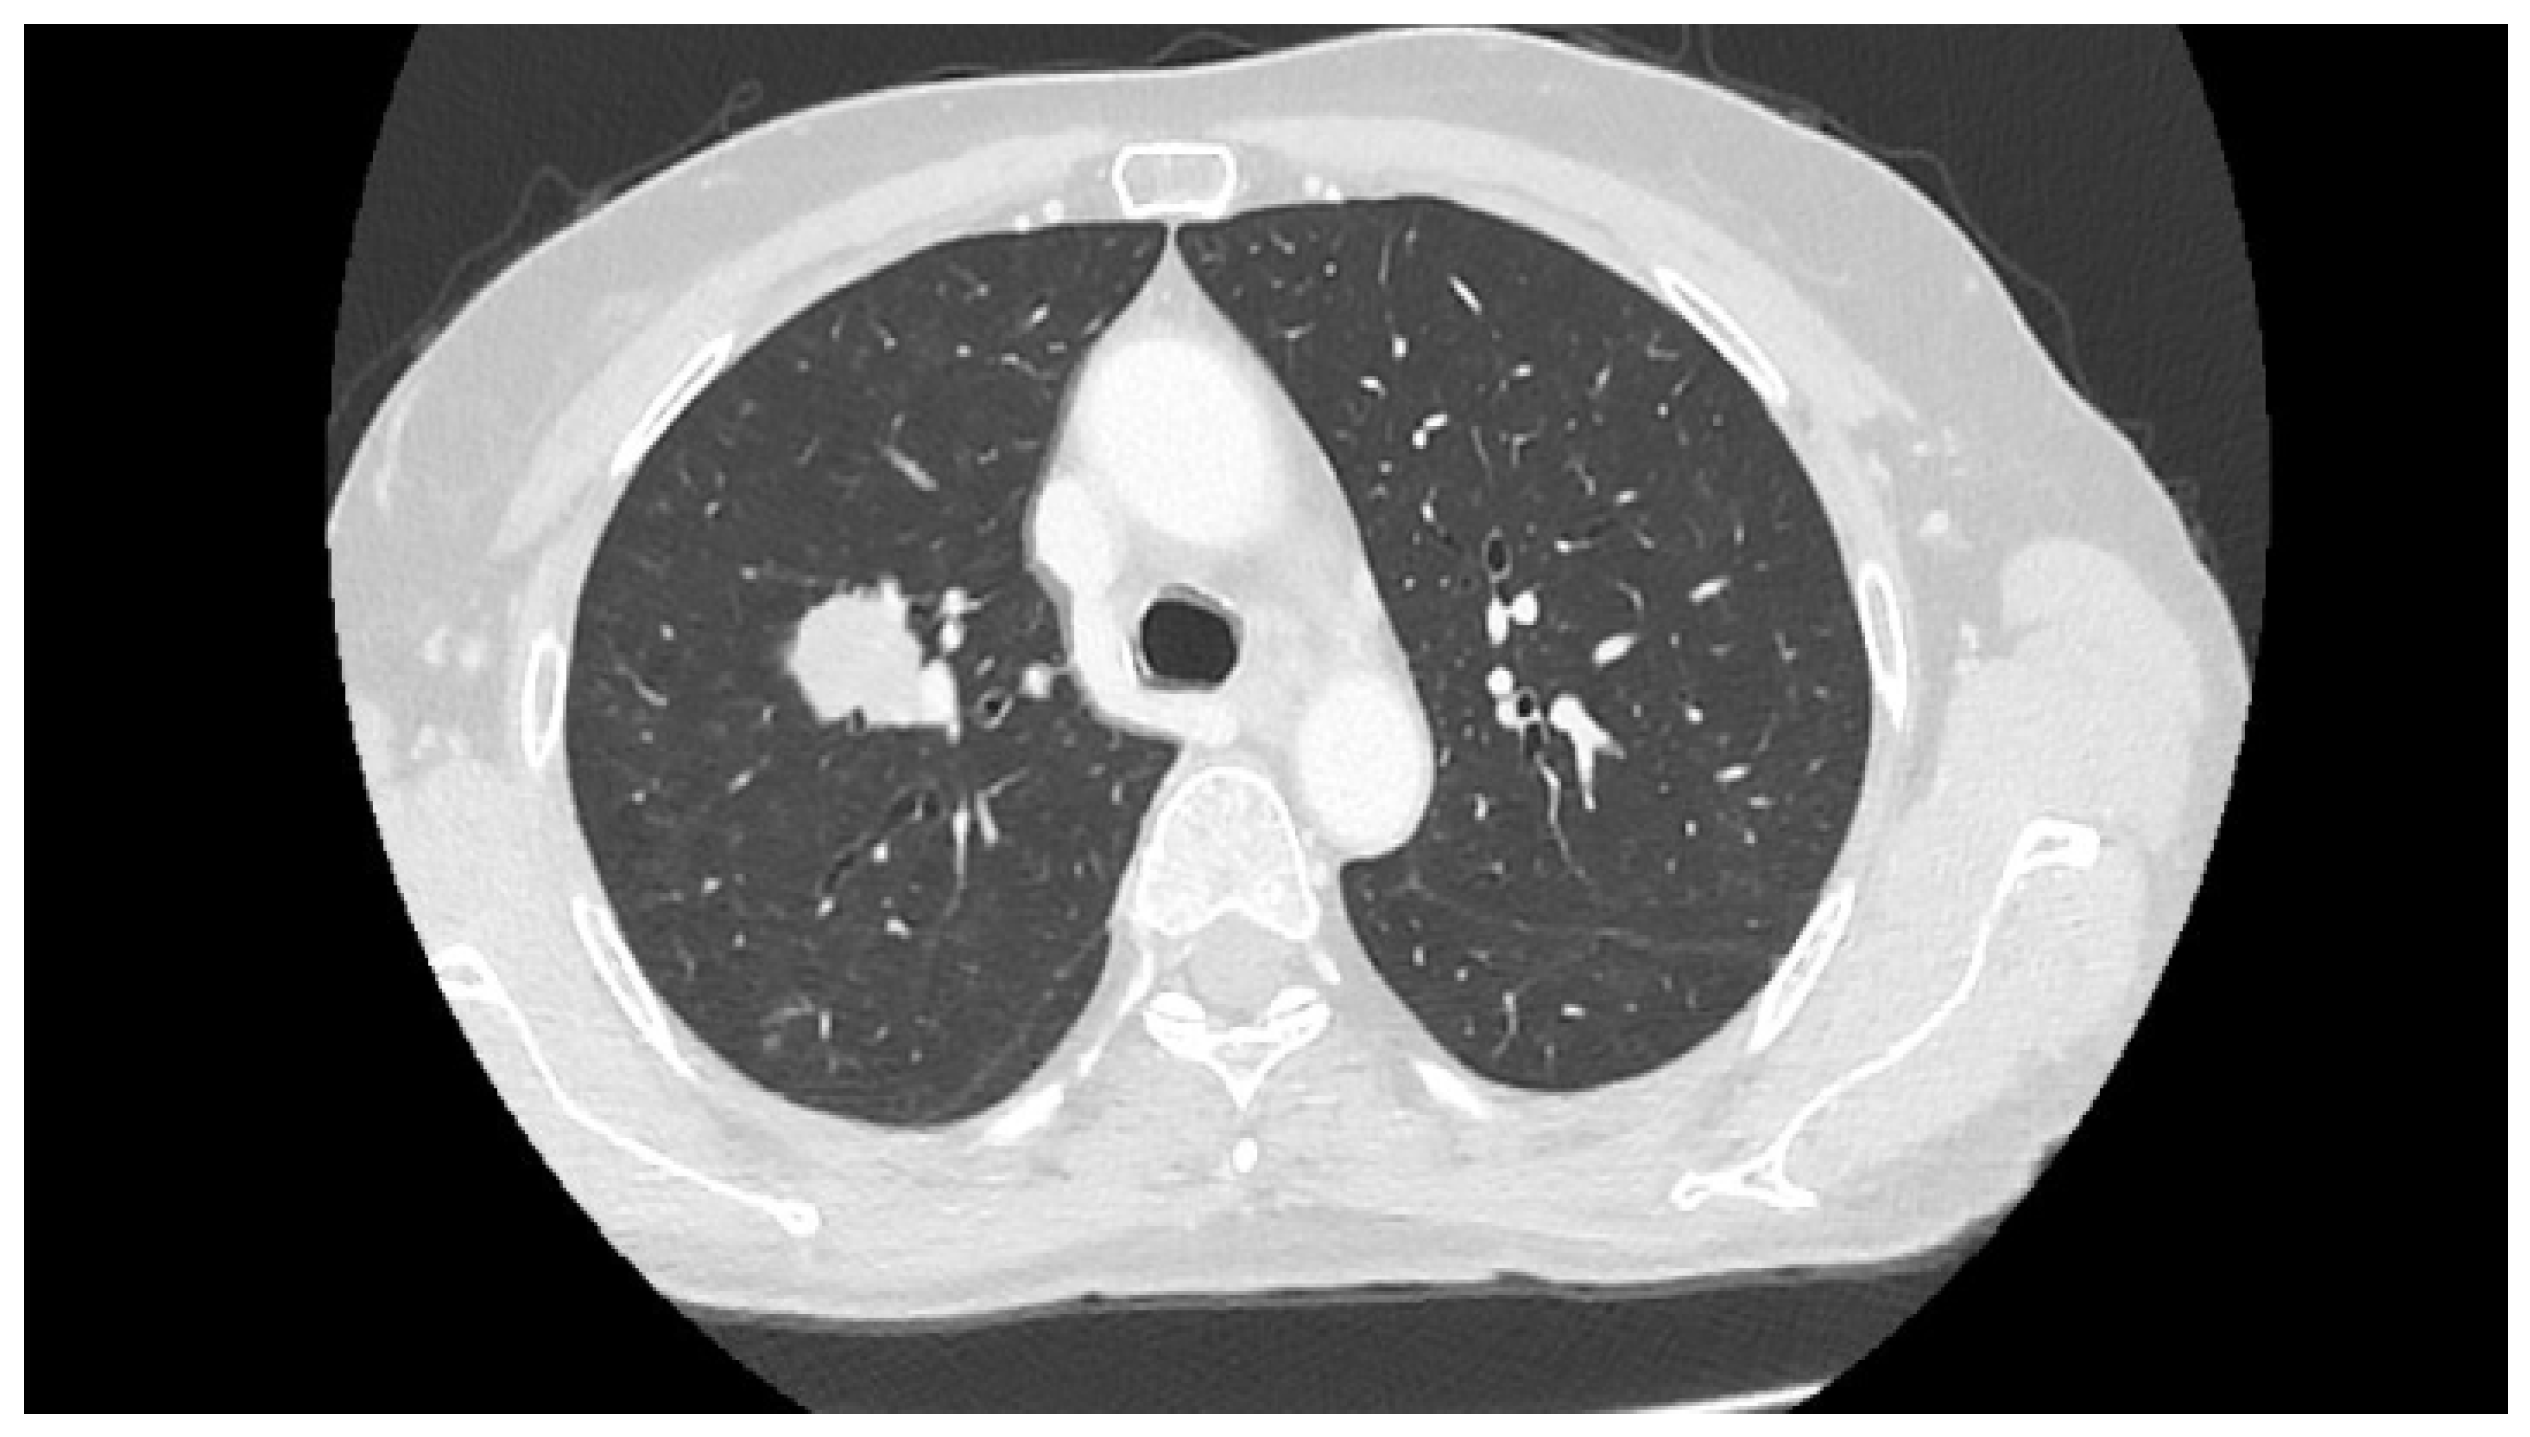

Next-Generation Sequencing Whole-Genome Analysis for Targeted Treatment Approach of Metastatic Bartholin Gland Adenocarcinoma: An Emblematic Case Report and Review of the Literature
Abstract
:1. Introduction
2. Case Report
3. Discussion
4. Conclusions
Author Contributions
Funding
Institutional Review Board Statement
Informed Consent Statement
Data Availability Statement
Acknowledgments
Conflicts of Interest
Appendix A
Appendix B
References
- Wohlmuth, C.; Wohlmuth-Wieser, I. Vulvar malignancies: An interdisciplinary perspective. J. Dtsch. Dermatol. Ges. 2019, 17, 1257–1276. [Google Scholar] [CrossRef] [Green Version]
- Ouldamer, L.; Chraibi, Z.; Arbion, F.; Barillot, I.; Body, G. Bartholin’s gland carcinoma: Epidemiology and therapeutic management. Surg. Oncol. 2013, 22, 117–122. [Google Scholar] [CrossRef] [PubMed]
- Visco, A.G.; Del Priore, G. Postmenopausal bartholin gland enlargement: A hospital-based cancer risk assessment. Obstet. Gynecol. 1996, 87, 286–290. [Google Scholar] [CrossRef]
- Leuchter, R.S.; Hacker, N.F.; Voet, R.L.; Berek, J.S.; Townsend, D.E.; Lagasse, L.D. Primary carcinoma of the Bartholin gland: A report of 14 cases and review of the literature. Obstet. Gynecol. 1982, 60, 361–368. [Google Scholar] [PubMed]
- Di Donato, V.; Casorelli, A.; Bardhi, E.; Vena, F.; Marchetti, C.; Muzii, L.; Benedetti Panici, P. Bartholin gland cancer. Crit. Rev. Oncol. Hematol. 2017, 117, 1–11. [Google Scholar] [CrossRef] [PubMed]
- Desouki, M.M.; Fadare, O. Primary adenocarcinomas of the vulva and related structures: An enigmatic and diverse group of tumors. Semin. Diagn. Pathol. 2021, 38, 71–84. [Google Scholar] [CrossRef]
- Cunningham, M.J.; Goyer, R.P.; Gibbons, S.K.; Kredentser, D.C.; Malfetano, J.H.; Keys, H. Primary radiation, cisplatin, and 5-fluorouracil for advanced squamous carcinoma of the vulva. Gynecol. Oncol. 1997, 66, 258–261. [Google Scholar] [CrossRef] [PubMed]
- Barcellini, A.; Gadducci, A.; Laliscia, C.; Imparato, S.; Vitolo, V.; Preda, L.; Valvo, F. Adenoid cystic carcinoma of Bartholin’s gland: What is the best approach? Oncology 2020, 98, 513–519. [Google Scholar] [CrossRef] [PubMed]
- Massad, L.S.; De Geest, K. Multimodality therapy for carcinoma of the Bartholin gland. Gynecol. Oncol. 1999, 75, 305–307. [Google Scholar] [CrossRef] [PubMed]
- Cardosi, R.J.; Speights, A.; Fiorica, J.V.; Grendys, E.C., Jr.; Hakam, A.; Hoffman, M.S. Bartholin’s gland carcinoma: A 15-year experience. Gynecol. Oncol. 2001, 82, 247–251. [Google Scholar] [CrossRef] [PubMed]
- Naumann, R.W.; Hollebecque, A.; Meyer, T.; Devlin, M.J.; Oaknin, A.; Kerger, J.; López-Picazo, J.M.; Machiels, J.P.; Delord, J.P.; Evans, T.R.J.; et al. Safety and efficacy of nivolumab monotherapy in recurrent or metastatic cervical, vaginal, or vulvar carcinoma: Results from the phase I/II Checkmate 358 trial. J. Clin. Oncol. 2019, 37, 2825–2834. [Google Scholar] [CrossRef] [PubMed]
- Frampton, G.M.; Fichtenholtz, A.; Otto, G.A.; Wang, K.; Downing, S.R.; He, J.; Schnall-Levin, M.; White, J.; Sanford, E.M.; An, P.; et al. Development and validation of a clinical cancer genomic profiling test based on massively parallel DNA sequencing. Nat. Biotechnol. 2013, 31, 1023–1031. [Google Scholar] [CrossRef]
- Mukherjee, R.; Vanaja, K.G.; Boyer, J.A.; Gadal, S.; Solomon, H.; Chandarlapaty, S.; Levchenko, A.; Rosen, N. Regulation of PTEN translation by PI3K signaling maintains pathway homeostasis. Mol. Cell 2021, 81, 708–723.e5. [Google Scholar] [CrossRef] [PubMed]
- Kato, S.; Okamura, R.; Adashek, J.J.; Khalid, N.; Lee, S.; Nguyen, V.; Sicklick, J.K.; Kurzrock, R. Targeting G1/S phase cell-cycle genomic alterations and accompanying co-alterations with individualized CDK4/6 inhibitor-based regimens. JCI Insight 2021, 6, e142547. [Google Scholar] [CrossRef] [PubMed]
- Goodman, A.M.; Sokol, E.S.; Frampton, G.M.; Lippman, S.M.; Kurzrock, R. Microsatellite-stable tumors with high mutational burden benefit from immunotherapy. Cancer Immunol. Res. 2019, 7, 1570–1573. [Google Scholar] [CrossRef] [PubMed] [Green Version]
- Gluskin, J.; Plodkowski, A.; Girshman, J.; Sarasohn, D.; Viteri-Jusué, A.; Hayan, S.; Torrisi, J. Waxing and waning pattern of mTOR inhibitor-associated pneumonitis in renal cell carcinoma patients: A retrospective observational study. Clin. Imaging 2021, 71, 29–33. [Google Scholar] [CrossRef]
- Copeland, L.J.; Sneige, N.; Gershenson, D.M.; McGuffee, V.B.; Abdul-Karim, F.; Rutledge, F.N. Bartholin gland carcinoma. Obstet. Gynecol. 1986, 67, 794–801. [Google Scholar] [CrossRef]
- Palisoul, M.L.; Mullen, M.M.; Feldman, R.; Thaker, P.H. Identification of molecular targets in vulvar cancers. Gynecol. Oncol. 2017, 146, 305–313. [Google Scholar] [CrossRef] [PubMed]
- Borella, F.; Preti, M.; Bertero, L.; Collemi, G.; Castellano, I.; Cassoni, P.; Cosma, S.; Carosso, A.R.; Bevilacqua, F.; Gallio, N.; et al. Is there a place for immune checkpoint inhibitors in vulvar neoplasms? A state of the art review. Int. J. Mol. Sci. 2020, 22, 190. [Google Scholar] [CrossRef] [PubMed]
- Ott, P.A.; Bang, Y.-J.; Piha-Paul, S.A.; Razak, A.R.A.; Bennouna, J.; Soria, J.-C.; Rugo, H.S.; Cohen, R.B.; O’Neil, B.H.; Mehnert, J.M.; et al. T-cell-inflamed gene-expression profile, programmed death ligand 1 expression, and tumor mutational burden predict efficacy in patients treated with pembrolizumab across 20 cancers: KEYNOTE-028. J. Clin. Oncol. 2019, 37, 318–327. [Google Scholar] [CrossRef]
- Madeddu, C.; Kotsonis, P.; Lavra, F.; Chiappe, G.; Melis, L.; Mura, E.; Scartozzi, M.; Macciò, A. Next generation sequencing driven successful combined treatment with laparoscopic surgery and immunotherapy for relapsed stage IVB cervical and synchronous stage IV lung cancer. Oncotarget 2019, 10, 2012–2021. [Google Scholar] [CrossRef]
- Macciò, A.; Madeddu, C. Future prospects for PD-1 targeting, macrophage infiltration, and IDO pathway activation in patients with sarcomas. JAMA Oncol. 2018, 4, 1134. [Google Scholar] [CrossRef] [PubMed]
- Holway, A.H.; Rieger-Christ, K.M.; Miner, W.R.; Cain, J.W.; Dugan, J.M.; Pezza, J.A.; Silverman, M.L.; Shapter, A.; McLellan, R.; Summerhayes, I.C. Somatic mutation of PTEN in vulvar cancer. Clin. Cancer Res. 2000, 6, 3228–3235. [Google Scholar]
- Kurzrock, R.; Ku, S.; Talpaz, M. Abnormalities in the PRAD1 (CYCLIN D1/BCL-1) oncogene are frequent in cervical and vulvar squamous cell carcinoma cell lines. Cancer 1995, 75, 584–590. [Google Scholar] [CrossRef]
- Williams, E.A.; Werth, A.J.; Sharaf, R.; Montesion, M.; Sokol, E.S.; Pavlick, D.C.; McLaughlin-Drubin, M.; Erlich, R.; Toma, H.; Williams, K.J.; et al. Vulvar squamous cell carcinoma: Comprehensive genomic profiling of HPV+ versus HPV− forms reveals distinct sets of potentially actionable molecular targets. JCO Precis. Oncol. 2020, 4, PO.19.00406. [Google Scholar] [CrossRef] [PubMed]
- Abbott, J.J.; Ahmed, I. Adenocarcinoma of mammary-like glands of the vulva: Report of a case and review of the literature. Am. J. Dermatopathol. 2006, 28, 127–133. [Google Scholar] [CrossRef]
- Nazeran, T.; Cheng, A.S.; Karnezis, A.N.; Tinker, A.V.; Gilks, C.B. Bartholin gland carcinoma: Clinicopathologic features, including p16 expression and clinical outcome. Int. J. Gynecol. Pathol. 2019, 38, 189–195. [Google Scholar] [CrossRef]
- Tessier-Cloutier, B.; Asleh-Aburaya, K.; Shah, V.; McCluggage, W.G.; Tinker, A.; Gilks, C.B. Molecular subtyping of mammary-like adenocarcinoma of the vulva shows molecular similarity to breast carcinomas. Histopathology 2017, 71, 446–452. [Google Scholar] [CrossRef] [PubMed]
- Grewal, J.K.; Eirew, P.; Jones, M.; Chiu, K.; Tessier-Cloutier, B.; Karnezis, A.N.; Karsan, A.; Mungall, A.; Zhou, C.; Yip, S.; et al. Detection and genomic characterization of a mammary-like adenocarcinoma. Cold Spring Harb. Mol. Case Stud. 2017, 3, a002170. [Google Scholar] [CrossRef] [PubMed] [Green Version]
- Simpson, L.; Parsons, R. PTEN: Life as a tumor suppressor. Exp. Cell Res. 2001, 264, 29–41. [Google Scholar] [CrossRef] [PubMed]
- Citi, V.; Del Re, M.; Martelli, A.; Calderone, V.; Breschi, M.C.; Danesi, R. Phosphorylation of AKT and ERK1/2 and mutations of PIK3CA and PTEN are predictive of breast cancer cell sensitivity to everolimus in vitro. Cancer Chemother. Pharmacol. 2018, 81, 745–754. [Google Scholar] [CrossRef]
- Zięba, S.; Kowalik, A.; Zalewski, K.; Rusetska, N.; Goryca, K.; Piaścik, A.; Misiek, M.; Bakuła-Zalewska, E.; Kopczyński, J.; Kowalski, K.; et al. Somatic mutation profiling of vulvar cancer: Exploring therapeutic targets. Gynecol. Oncol. 2018, 150, 552–561. [Google Scholar] [CrossRef] [PubMed]
- Jerusalem, G.; de Boer, R.H.; Hurvitz, S.; Yardley, D.A.; Kovalenko, E.; Ejlertsen, B.; Blau, S.; Özgüroglu, M.; Landherr, L.; Ewertz, M.; et al. Everolimus plus exemestane vs everolimus or capecitabine monotherapy for estrogen receptor-positive, HER2-negative advanced breast cancer: The BOLERO-6 randomized clinical trial. JAMA Oncol. 2018, 4, 1367–1374. [Google Scholar] [CrossRef]
- Baselga, J.; Campone, M.; Piccart, M.; Burris, H.A., 3rd; Rugo, H.S.; Sahmoud, T.; Noguchi, S.; Gnant, M.; Pritchard, K.I.; Lebrun, F.; et al. Everolimus in postmenopausal hormone-receptor-positive advanced breast cancer. N. Engl. J. Med. 2012, 366, 520–529. [Google Scholar] [CrossRef] [Green Version]
- Elvin, J.A.; Gay, L.M.; Ort, R.; Shuluk, J.; Long, J.; Shelley, L.; Lee, R.; Chalmers, Z.R.; Frampton, G.M.; Ali, S.M.; et al. Clinical benefit in response to palbociclib treatment in refractory uterine leiomyosarcomas with a common CDKN2A alteration. Oncologist 2017, 22, 416–421. [Google Scholar] [CrossRef] [PubMed] [Green Version]
- Gao, J.; Adams, R.P.; Swain, S.M. Does CDKN2A loss predict palbociclib benefit? Curr. Oncol. 2015, 22, e498–e501. [Google Scholar] [CrossRef] [PubMed] [Green Version]
- Chen, Y.; Li, Z.; Fang, Q.; Wang, H.; Li, C.; Gao, H.; Zhang, Y. CDKN2A (p16INK4A) affects the anti-tumor effect of CDK inhibitor in somatotroph adenomas. Int. J. Mol. Med. 2021, 47, 500–510. [Google Scholar] [CrossRef] [PubMed]
- Jeong, E.H.; Lee, T.G.; Ko, Y.J.; Kim, S.Y.; Kim, H.R.; Kim, H.; Kim, C.H. Anti-tumor effect of CDK inhibitors on CDKN2A-defective squamous cell lung cancer cells. Cell. Oncol. 2018, 41, 663–675. [Google Scholar] [CrossRef] [PubMed]
- DeMichele, A.; Clark, A.S.; Tan, K.S.; Heitjan, D.F.; Gramlich, K.; Gallagher, M.; Lal, P.; Feldman, M.; Zhang, P.; Colameco, C.; et al. CDK 4/6 inhibitor palbociclib (PD0332991) in Rb+ advanced breast cancer: Phase II activity, safety, and predictive biomarker assessment. Clin. Cancer Res. 2015, 21, 995–1001. [Google Scholar] [CrossRef] [PubMed] [Green Version]
- Johnson, D.B.; Dahlman, K.H.; Knol, J.; Gilbert, J.; Puzanov, I.; Means-Powell, J.; Balko, J.M.; Lovely, C.M.; Murphy, B.A.; Goff, L.W.; et al. Enabling a genetically informed approach to cancer medicine: A retrospective evaluation of the impact of comprehensive tumor profiling using a targeted next-generation sequencing panel. Oncologist 2014, 19, 616–622. [Google Scholar] [CrossRef] [PubMed] [Green Version]
- Fu, S.; Shi, N.; Wheler, J.; Naing, A.; Janku, F.; Piha-Paul, S.; Gong, J.; Hong, D.; Tsimberidou, A.; Zinner, R.; et al. Characteristics and outcomes for patients with advanced vaginal or vulvar cancer referred to a phase I clinical trials program: The MD Anderson cancer center experience. Gynecol. Oncol. Res. Pract. 2015, 2, 10. [Google Scholar] [CrossRef] [Green Version]

| Genomic Signature | Result |
|---|---|
| Microsatellite status | MS-stable |
| Tumor mutational burden | 3 mutations/Mb |
| Gene (encoded protein) | Alteration |
| CCND1 (cyclin D1) | Amplification |
| PTEN (phosphatase and tensin homologue) | Loss of exons 2–5 |
| MDM2 (E3 ubiquitin protein ligase Mdm2) | Amplification |
| CDKN2A/B (p16INK4a, p14ARF, p15INK4b) | Loss |
| FGF19 (fibroblast growth factor 19) | Amplification |
| FGF3 (fibroblast growth factor 3) | Amplification |
| FGF4 (fibroblast growth factor 4) | Amplification |
| IKBKE (I-kappa-B kinase epsilon) | Amplification |
| MCL1 (myeloid cell leukemia 1) | Amplification |
| MTAP (S-methyl-5′-thioadenosine phosphorylase) | Loss |
| NFKBIA (NFkappaB inhibitor IkBA) | Amplification |
| Gene | Mutation |
|---|---|
| BCL2 | E29Q |
| CARD11 | R555W |
| DNMT3A | V501I |
| ERBB3 | L1177I |
| FAM123B | H134P |
| FANCA | Rearrangement |
| FGFR3 | V117I |
| GNAS | T415_G423del |
| KDR | V159M |
| KIT | E366D and rearrangement |
| MED12 | Q2119_Q2120insHQQQ |
| MSH3 | F71I |
| PIK3C2B | L889F |
| SOCS1 | G122R |
Publisher’s Note: MDPI stays neutral with regard to jurisdictional claims in published maps and institutional affiliations. |
© 2021 by the authors. Licensee MDPI, Basel, Switzerland. This article is an open access article distributed under the terms and conditions of the Creative Commons Attribution (CC BY) license (https://creativecommons.org/licenses/by/4.0/).
Share and Cite
Macciò, A.; Donisi, C.; Sanna, E.; Chiappe, G.; Nemolato, S.; Melis, L.; Oppi, S.; Mola, B.; Madeddu, C. Next-Generation Sequencing Whole-Genome Analysis for Targeted Treatment Approach of Metastatic Bartholin Gland Adenocarcinoma: An Emblematic Case Report and Review of the Literature. Diagnostics 2021, 11, 2085. https://doi.org/10.3390/diagnostics11112085
Macciò A, Donisi C, Sanna E, Chiappe G, Nemolato S, Melis L, Oppi S, Mola B, Madeddu C. Next-Generation Sequencing Whole-Genome Analysis for Targeted Treatment Approach of Metastatic Bartholin Gland Adenocarcinoma: An Emblematic Case Report and Review of the Literature. Diagnostics. 2021; 11(11):2085. https://doi.org/10.3390/diagnostics11112085
Chicago/Turabian StyleMacciò, Antonio, Clelia Donisi, Elisabetta Sanna, Giacomo Chiappe, Sonia Nemolato, Luca Melis, Sara Oppi, Brunella Mola, and Clelia Madeddu. 2021. "Next-Generation Sequencing Whole-Genome Analysis for Targeted Treatment Approach of Metastatic Bartholin Gland Adenocarcinoma: An Emblematic Case Report and Review of the Literature" Diagnostics 11, no. 11: 2085. https://doi.org/10.3390/diagnostics11112085
APA StyleMacciò, A., Donisi, C., Sanna, E., Chiappe, G., Nemolato, S., Melis, L., Oppi, S., Mola, B., & Madeddu, C. (2021). Next-Generation Sequencing Whole-Genome Analysis for Targeted Treatment Approach of Metastatic Bartholin Gland Adenocarcinoma: An Emblematic Case Report and Review of the Literature. Diagnostics, 11(11), 2085. https://doi.org/10.3390/diagnostics11112085

